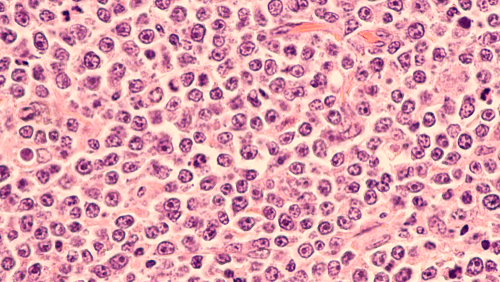

Longer term data validate durable responses with Tisagenlecleucel in adults with relapsed and refractory DLBCL
American Society of Hematology Newsroom Dec 05, 2018
More than 18 months after patients with relapsed or treatment-resistant diffuse large B-cell lymphoma (DLBCL) were treated with a single dose of tisagenlecleucel, high response rates persist, further demonstrating that this therapy is beneficial for many patients who otherwise wouldn’t have a viable option for treatment.
In this latest follow-up analysis of the international JULIET trial, 19-month results show the overall response rate was 54 percent among 99 patients who were followed for at least three months or discontinued therapy early, with 40 percent achieving a complete response and 16 percent achieving a partial response. Moreover, 64 percent of patients who achieved a complete response earlier in the trial are currently still in remission with no detectable evidence of cancer. Median duration of response and median overall survival in responding patients was not reached. Response rates were consistent across subgroups of patients, including the elderly and those with particularly aggressive lymphoma (double-/triple-hit) or prior stem cell transplantation.
“We’re seeing that the responses are sustained. There are a significant number of patients who are staying free of disease, and none of the patients in remission have proceeded on to transplantation,” said lead study author Richard Thomas Maziarz, MD, of the Oregon Health & Science Knight Cancer Institute, in Portland, Oregon.
DLBCL is the most common form of lymphoma, accounting for roughly one-third of all non-Hodgkin lymphoma cases. While current treatment options are successful for many people with this disease, primary therapy often fails in about one-third of people with DLBCL, and half of these patients won’t be eligible for stem cell transplantation, which is considered the best second-line treatment approach. Such patients would be candidates for this type of therapy. JULIET trial data were used to justify the U.S. Food and Drug Administration (FDA) approval of tisagenlecleucel for this patient population in May 2018. Additional approvals followed this year in the European Union, Switzerland, and Canada.
This single-arm, open-label Phase II trial is among the largest studies to examine a CAR T-cell therapy exclusively in people with DLBCL. It was conducted at 27 treatment sites spanning 10 countries across North America, Europe, Australia, and Asia. Enrollees had to receive two or more previous treatments with documented disease progression, or failed to respond or were otherwise ineligible for autologous stem cell transplant. A total of 115 patients were successfully infused. Patients ranged in age from 22-76 years old with a median age of 56.
Of note, 54 percent of patients who initially had a partial response ended up having a complete response, which suggests that the cell product persists viably and remains active in vivo over time, according to Dr. Maziarz.
Consistent with previous reports on safety, most of the severe adverse events were seen shortly after infusion and included drop in mature blood cells (34% of patients), CRS (23% of patients), infection (19% of patients), and neurological events (11% of patients). There were no deaths that investigators attributed to the therapy.
Patients in the JULIET trial who responded to therapy will continue to be followed. Dr. Maziarz said that as research evolves, the focus will need to be on approaches for optimizing the outcomes of therapy, such as combination therapy with checkpoint inhibitors or other targeted therapy to enhance, maintain, or stimulate their responses.
“We’re changing the natural history of the disease, and identifying subpopulations of patients who may need therapies in addition to CAR-T will be an important next step,” he said. “This research is really the foundation for the next wave of studies to assess combination therapies.”
Funding for this study was provided by Novartis.
This article is a press release of a study presented at the 60th American Society of Hematology (ASH) Annual Meeting and Exposition, 2018. Read the original here.
-
Exclusive Write-ups & Webinars by KOLs
-
Daily Quiz by specialty
-
Paid Market Research Surveys
-
Case discussions, News & Journals' summaries